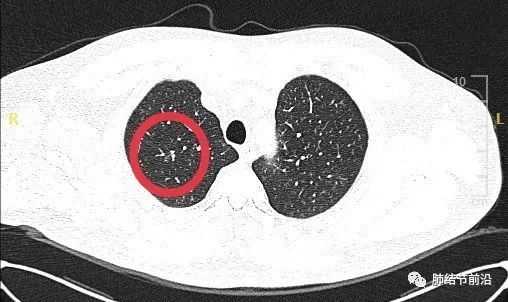

肺结节读片(33):这就是实性结节的“边界毛糙”和“分叶”
33岁男性,首次发现右上肺实性结节11mm,吸烟史,无家族史,CT如下。

实验室检查:CEA(-)。
实性结节是诊断难点。该结节位于上叶,怎样和结核和慢性炎症鉴别?
主要还是看CT影像。首先看边界,有典型的边界毛糙,短毛刺,这个是肺癌的特征性表现。

并且,结节分叶很深。

根据这两个关键影像学特点,需要高度怀疑肺癌,而且为恶性程度较高的腺癌。
对于大于8mm的实性结节,特别是CT有恶性特征的结节,不建议随访,需要早期进一步检查。
建议患者行PETCT,为明显高代谢,即刻建议外科手术切除。
术后病理为浸润性腺癌,肺泡及微乳头型,淋巴结无转移,有ROS1突变。肿瘤最大直径为11mm,最后分期为pT1bN0M0,IA2期。

该病例显示了CT影像对于实性结节的诊断意义,高清薄层CT可以显示结节边界,毛糙者为恶性特征,深分叶提示恶性程度高。大于8mm的可疑恶性实性结节,可以做PET-CT。术后证实为腺泡型及微乳头腺癌。